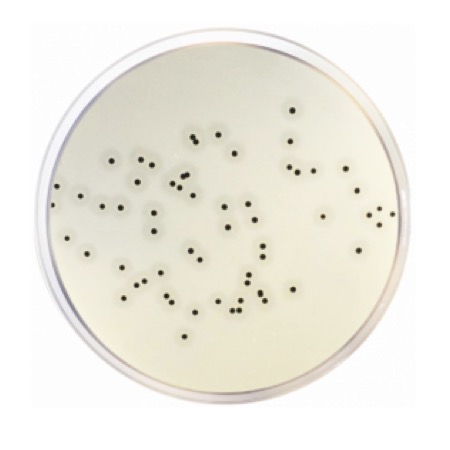
product

Nutrient Agar ISO is a non-selective culture medium used for routine cultivation, enumeration and maintenance of non-fastidious bacteria. It is suitable for food, water and environmental microbiology and is prepared according to ISO requirements. The medium supports reliable growth of a wide range of microorganisms and is commonly used for total viable count and general laboratory applications.
Nutrient Agar ISO (catalogue number 1060) is a dehydrated, non-selective solid culture medium intended for the cultivation and enumeration of non-fastidious microorganisms. It is widely used in food, water, environmental and general laboratory microbiology for routine quality control and microbiological testing.
The medium provides essential nutrients required for bacterial growth and allows development of a broad spectrum of aerobic microorganisms. After preparation and sterilization, it is suitable for pour plate or surface inoculation techniques. Nutrient Agar ISO complies with ISO standards for microbiological analysis.
Advantages
- General-purpose, non-selective medium for routine microbiological analysis.
- Suitable for total viable count and cultivation of non-fastidious bacteria.
- Applicable to food, water and environmental microbiology.
- Simple preparation and consistent performance.
Technical specifications
| Catalogue number | 1060 |
| Pack size | 500 g |
| Medium type | Dehydrated culture medium (agar) |
| Selectivity | Non-selective |
| Standards compliance | ISO |
| Intended use | Cultivation and enumeration of non-fastidious microorganisms |
| Application areas | Food, water, environmental and laboratory microbiology |
| Storage conditions | Store tightly closed in a dry place, 2–25 °C |
| Chemical type | Microbial Culture Media |
| Brand | Condalab |
| Pack size | 500 g |